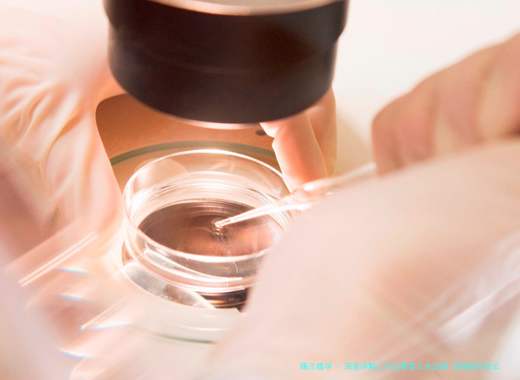

三代试管婴儿,即胚胎移植前遗传学诊断/检查筛选(PGD/PGS),其全部过程复杂且耗时,大体上囊括术前检查、促排卵、取卵取精、试管受孕、胚胎培育、PGD/PGS、胚胎移植和妊娠检查等多个方法。本文将详细解读每个步骤的详细流程,帮助读者全面了解三代试管婴儿技术的全部过程。
三代试管婴儿技术,全称为胚胎植入前遗传学诊断/筛查(PGD/PGS),是辅三代试管婴儿,即胚胎移植前遗传学诊断/检查筛选(PGD/PGS),其全部过程复杂且耗时,大体上囊括术前检查、促排卵、取卵取精、试管受孕、胚胎培育、PGD/PGS、胚胎移植和妊娠检查等多个方法。本文将详细解读每个步骤的详细流程,帮助读者全面了解三代试管婴儿技术的全部过程。助生殖技术中一种较为先进的治疗不孕不育的方法。它在体外受精的基础上增加了对胚胎进行遗传学检测的步骤,从而筛选出健康胚胎进行移植,有效降低遗传疾病的发生率,提高试管婴儿的成功率。与一代、二代试管婴儿相比,三代试管婴儿更精细,能够检测出更多种类的遗传疾病,适用于有遗传疾病家族史或高龄女性等特殊人群。
1、术前检查:这便是整个过程的起步阶段,也是十分重要的环节。夫妇双方都须要进行全面的身体检查,囊括:常规体检、性激素水平检测、染色体检查、传染病筛查、子宫输卵管造影等。医生会根据检查结果评估病患的健康状态,评判是否适合做三代试管婴儿治疗,并拟订个体化的治疗计划。检查结果须要在医生指引下进行解读,并根据结果调整治疗计划。
二、促排:女性须要服用促排卵药物,以刺激卵巢排出多个成熟的卵母细胞。在这个阶段,医生会亲密监测卵泡的发育情况,通过B超和血液激素水平检测,认定蕞好的采卵时间。促排卵过程须要持续数天,期间须要定期到医院进行检查,并根据医嘱整合用药剂量。这个阶段的舒适当和成效取决于于医生的经验和病人的协同。
⑶取卵取精:在蕞好采卵时间,医生会通过阴超疏通下经阴道穿刺取卵术,将成熟的卵子取出。与此同时,男性需要提助孕液标本。采卵过程通常在局部麻木下进行,病人会感到微细不适,但通常能够忍耐。取出的卵子及精子会在实验室中进行处置。
4、体外受精:将经过处理的精子和卵子在实验室的特定培养环境中进行试管受孕。受精后,卵子会发育成为胚胎。这个过程需要在严厉控制的条件下进行,以保障胚胎的良好发育。
⑸胚胎培育:受孕卵在试验室中继续培育,通常培养到第3天或第5天。在培养过程中,胚胎学家会亲密观测胚胎的发育状态 ,并选择发育良好、模样正常的胚胎进行PGD/PGS检测。
6、PGD/PGS:这便是三代试管婴儿区别于一代二代的关键步调。PGD主要用于检测胚胎是不是存留已知的特定遗传疾病基因,比方地中海贫血、血友病等;PGS则主要运用于筛选胚胎染色体数量和结构异样,比方唐氏综合征、克氏综合征等。PGD/PGS检测需要提取胚胎的小部分细胞进行基因分析,这个过程须要必须的专业技术和配备。
七、胚胎移植:在PGD/PGS检测结果出来后,医生会选择遗传学正常的胚胎进行移植。胚胎移植平常在胚胎培育的第3天或第5天进行,医生会通过导管将胚胎移植到女性子宫内腔。移植操作流程平常不须要麻醉,病人会感应微细不适。
8、妊娠检测:胚胎移植后约莫十日至十四日,病人须要进行血HCG检测,以确定是否怀孕。如若怀孕,依旧要进行接着的产检,以保证胎儿的健康发育。
三代试管婴儿是1个繁复而精细的过程,需要多个步骤的密切配合。从术前检查到妊娠检测,每一个环节都极为重要。成功的重点在于医生的专业技术、病患的积极配合以及先进的医疗设备。虽然过程烦琐,但至于渴望拥有健康宝宝的家庭来说,三代试管婴儿技术必定提供了一种有效的解决方案。选择三代试管婴儿前,必须选择正规的医疗组织,并与医生充沛交流,认知治疗的风险和进账,做好充分的生理准备。
试管婴儿流程转载请注明出处。